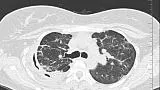
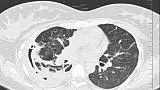

- Компании
- Takeda. О компании, буклеты, каталоги, контакты
- Olympus. О компании, буклеты, каталоги, контакты
- Boston Scientific. О компании, буклеты, каталоги, контакты
- Pentax. О компании, буклеты, каталоги, контакты
- Fujifilm & R-Farm. О компании, буклеты, каталоги, контакты
- Erbe. О компании, буклеты, каталоги, контакты
- Еще каталоги
- Мероприятия
- Информация
- Обучение
- Классификации
- Атлас
- Quiz
- Разделы
- Пациенту
QR-код этой страницы
Для продолжения изучения на мобильном устройстве ПРОСКАНИРУЙТЕ QR-код с помощью спец. программы или фотокамеры мобильного устройства
Клинические случаи: Повторная блокация промежуточного бронха

Полный текст статьи:
08.06.2020 проведена повторная установка блокатора в промежуточный бронх (блокатор Medlung №13) с хорошим клиническим эффектом (сброс воздуха по плевральному дренажу прекратился через 8 часов после вмешательства). Подтверждено данными Р-КТ органов грудной клетки.
Рекомендуемые статьи
При эндоскопическом исследовании в случае бронхоэктазов в стадии ремиссии выявляется
частично диффузный бронхит I степени воспаления
Активируйте PUSH уведомления в браузер
Отключите PUSH уведомления в браузер
Содержание
Интернет магазин
Популярное
- О нас
- Правовые вопросы
- Политика
обработки персональных
данных EndoExpert.ru - Связаться с нами
- Стать партнером
© 2016-2022 EndoExpert.ru

Вы находитесь в разделе предназначенном только для специалистов (раздел для пациентов по ссылке). Пожалуйста, внимательно прочитайте полные условия использования и подтвердите, что Вы являетесь медицинским или фармацевтическим работником или студентом медицинского образовательного учреждения и подтверждаете своё понимание и согласие с тем, что применение рецептурных препаратов, обращение за той или иной медицинской услугой, равно как и ее выполнение, использование медицинских изделий, выбор метода профилактики, диагностики, лечения, медицинской реабилитации, равно как и их применение, возможны только после предварительной консультации со специалистом. Мы используем файлы cookie, чтобы предложить Вам лучший опыт взаимодействия. Файлы cookie позволяют адаптировать веб-сайты к вашим интересам и предпочтениям.
Я прочитал и настоящим принимаю вышеизложенное, хочу продолжить ознакомление с размещенной на данном сайте информацией для специалистов.













.jpg)




.png)



















Комментарии